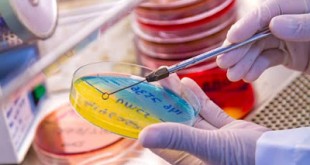

του Αλέξανδρου Γιατζίδη, διευθυντή σύνταξης, medlabnews.gr Σας παρουσιάζω δύο ιστορίες, μία πρόσφατη και μία λίγο πιο γλαφυρή που όμως δείχνουν με διαφορετικό τρόπο τι τραβούν τα τελευταία χρόνια οι εργαστηριακοί γιατροί από τον ΕΟΠΥΥ. Ιστορία Πρώτη Τον Νοέμβριο σε εργαστηριακό γιατρό της Αθήνας (έχουμε το όνομα) τον παίρνουν από τον …
ΠερισσότεραΕπίσχεση εργαστηριακών ιατρών: η γλώσσα της αλήθειας και των αριθμών
Για όσους δυσκολεύονται να συνειδητοποιήσουν το πραγματικό πολιτικοοικονομικό περιβάλλον που ζούμε, παρατίθενται ιστορικά δεδομένα από την έναρξη λειτουργίας του ΕΟΠΥΥ το 2012 έως σήμερα, με εναλλαγή όλων των κυβερνήσεων, των Υπουργών Υγείας και των διοικήσεων του ΕΟΠΥΥ της τελευταίας πενταετίας : 1. Τα μέτρα εξορθολογισμού των δαπανών των διαγνωστικών εξετάσεων …
ΠερισσότεραΑύξηση 15% στην συμμετοχή των ασφαλισμένων του ΕΟΠΥΥ, με απόφαση του Υπουργείου Υγείας
του Αλέξανδρου Γιατζίδη, διευθυντή σύνταξης των medlabnews.gr και iatrikanea.gr Τυράκι στους εργαστηριακούς γιατρούς, που βρίσκονται σε αναβρασμό και επίσχεση εργασίας, αποτελεί η υπ. Αριθ. Γ3γ/οικ. 12146 απόφαση του Αναπληρωτή Υπουργού Υγείας κ. Παύλου Πολάκη, για αύξηση κατά 15% στη συμμετοχή των ασφαλισμένων του ΕΟΠΥΥ. Συγκεκριμένα με βάση την απόφαση …
ΠερισσότεραΟ ΙΣΑ απαντά στις καταγγελίες του ΕΟΠΥΥ κατά γιατρών για θέματα συνταγογράφησης
Mε αφορμή καταγγελίες του ΕΟΠΥΥ κατά γιατρών για θέματα συνταγογράφησης ο Ιατρικός Σύλλογος Αθηνών επισημαίνει τα εξής: Οι δήθεν επιστημονικοί περιορισμοί για τους γιατρούς στο σύστημα συνταγογράφησης σκοπό έχουν κατά βάση να δυσκολέψουν τους ασθενείς στην πρόσβασή τους στο φάρμακο. Στόχος είναι να υλοποιηθεί η δέσμευση απέναντι στην τρόικα για …
ΠερισσότεραΤα εισιτήρια και άλλα τα αυξάνουν αλλά τις ιατρικές εξετάσεις τις μείωσαν. Επιβάλλεται αποκατάσταση της στρέβλωσης
του Αλέξανδρου Γιατζίδη, medlabnews.gr Για άλλη μια φορά αυξήθηκαν τα εισιτήρια των Αστικών συγκοινωνιών κατά 16% επιβαρύνοντας την τσέπη του πολίτη που κινήται με αυτές. Ενδιαφέρον έχει ότι αυτό συνέβει παρόλο, που τα καύσιμα πέφτουν καθημερινά και έχουν διεθνώς οι τιμές του πετρελαίου καταβαραθρωθεί. Όμως από την περασμένη εβδομάδα και …
ΠερισσότεραΤο τεστ ανίχνευσης Η1Ν1, θα καλύπτεται από τον ΕΟΠΥΥ
Όπως είναι γνωστό, μέχρι σήμερα το κόστος της ειδικής εξέτασης για την ανίχνευση του ιού Η1Ν1 το πλήρωναν οι ασθενείς από την τσέπη τους. Χθες, ο υπουργός Υγείας, Α. Ξανθός έδωσε εντολή στη Διοίκηση του ΕΟΠΥΥ το εν λόγω κόστος για όλους τους ασθενείς που νοσηλεύονται στα δημόσια νοσοκομεία της …
ΠερισσότεραΝόμιμο και Ηθικό, Παράνομο και Ανήθικο η μήπως τελικά μπορεί το Νόμιμο να είναι Ανήθικο και το παράνομο ηθικό;
του Λεωνίδα Αναγνώστου Πρόσφατα οι Υπουργοί Υγείας (Ξανθός Πολάκης) υπέγραψαν μια Υπουργική απόφαση κατ’ εντολή των επικυρίαρχων Ευρωπαίων δανειστών ως προαπαιτούμενο της δόσης Δεκεμβρίου με την οποίαν υποκοστολογούν τις Ιατρικές Εργαστηριακές Πράξεις μεσοσταθμικά κατά 43-46 %. Σημειωτέων ότι το 2013 είχε προηγηθεί μια άλλη μείωση των ίδιων εξετάσεων πάλι …
ΠερισσότεραΑχ κακόμοιρε μικροβιολόγε…… Ετσι που σε κατάντησαν Κλείστο…. για να γλυτώσεις, είπε ο λογιστής
του Αλέξανδρου Γιατζίδη, διευθυντή σύνταξης, medlabnews.gr ▪ Γνωρίζετε ότι για μια χοληστερίνη ο ΕΟΠΥΥ θα πληρώνει τον γιατρό 0,36 Ευρώ και αυτό με καθυστέρηση 5 με 6 μηνών; ▪ Γνωρίζετε ότι υπάρχουν φορές που το παραπεμπτικό που αφήνετε στον μικροβιολόγο, o EOΠΥΥ δεν το πληρώνει ΠΟΤΕ; ▪ Γνωρίζετε ότι όποιες …
ΠερισσότεραΑδύνατη η εξυπηρέτηση των ασφαλισμένων από τους ιατρούς του ΕΟΠΥΥ από 01-01-2016 εάν δεν εκδοθεί ΦΕΚ παράτασης των συμβάσεων
Πραγματοποιήθηκε συνάντηση της ΕΝΙ ΕΟΠΥΥ με τον Πρόεδρο του ΕΟΠΥΥ, κ Μπερσίμη και τον Αντιπρόεδρο του ΕΟΠΥΥ, κ. Γεωργακόπουλο στις 18/12/2015 παρουσία διοικητικών στελεχών και συνεργατών του Οργανισμού. Τέθηκαν επί τάπητος όλα τα θέματα που απασχολούν τους συμβεβλημένους ιατρούς, με πρωταρχικό, τη μεγάλη στάση πληρωμών του Οργανισμού, που έχει ως αποτέλεσμα την έντονη οικονομική δυσπραγία τους. Κατατέθηκε …
Περισσότερα10 λόγοι που χιλιάδες εργαστηριακοί γιατροί οδηγούνται στον αφανισμό. Ο εκβιασμός για μείωση των τιμών έπιασε και το σχέδιο ντόπιων και τρόικας είναι σε πλήρη εξέλιξη
του Αλέξανδρου Γιατζίδη, διευθυντή σύνταξης, medlabnews.gr Η υποκοστολόγιση των τιμών των εξετάσεων, θα αναγκάσει χιλιάδες γιατρούς να βρεθούν χωρίς δουλειά σύντομα και χωρίς τη δυνατότητα να αντεπεξέλθουν στις μεγάλες υποχρεώσεις που έχουν φορτωθεί. Τελικά υπό την πίεση να μην εκταμιευθεί το ένα δισεκατομμύριο ευρώ και παρά την μεγάλη κινητοποίηση του …
ΠερισσότεραΟι άνθρωποι που ζουν με ηπατίτιδα C, πιο μακριά από ποτέ από την θεραπεία
Σε καθημερινή βάση δεχόμαστε καταγγελίες από ασθενείς που ζουν με ηπατίτιδα C, σχετικά με τα εμπόδια που αντιμετωπίζουν στην πρόσβαση για τα καινούργια φάρμακα για την αντιμετώπιση της ηπατίτιδας C. Τα κριτήρια πρόσβασης που έχει θέσει ο ΕΟΠΥΥ, είναι περιοριστικά και σαφώς δεν συνάδουν με τα νεότερα επιστημονικά δεδομένα, τις …
ΠερισσότεραΟ ΙΣΑ κοινοποίησε την πρώτη εξώδικη διαμαρτυρία κατά του ΕΟΠΥΥ για τα ληξιπρόθεσμα των ταμείων για τα έτη 2010-2011
O Ιατρικός Σύλλογος Αθηνών κοινοποίησε την πρώτη εξώδικη δήλωση-διαμαρτυρία για τη μη καταβολή των ληξιπρόθεσμων οφειλών των ταμείων που εντάχθηκαν στον ΕΟΠΥΥ. Στο παρόν επισυνάπτεται το από 15/12/2015 εξώδικο, στο οποίο συμμετέχουν 450 μέλη του ΙΣΑ και από το οποίο έχουν απαλειφθεί τα ονόματα τους, για λόγους προσωπικών δεδομένων. Τις …
ΠερισσότεραΣκιές στην επιλογή του νέου προέδρου του ΕΟΠΥΥ
Ενας λέκτορας, χωρίς καμία ουσιαστική διοικητική εμπειρία, αναλαμβάνει τα ηνία του ΕΟΠΥΥ, ενός οργανισμού υπεύθυνου για την ιατροφαρμακευτική περίθαλψη περίπου εννέα εκατομμυρίων ασφαλισμένων, με προϋπολογισμό πάνω από 5 δισεκατομμύρια ευρώ και ληξιπρόθεσμες οφειλές που ξεπερνούν το 1,8 δισ. ευρώ. Ο 40χρονος Σωτήρης Μπερσίμης, εκλεκτός του Μεγάρου Μαξίμου για τη θέση …
ΠερισσότεραΣυνάντηση Υπουργού Υγείας με τον Γενικό Διευθυντή του ΕΟΠΥΥ
ο Υπουργός Υγείας Θάνος Δημόπουλος συναντήθηκε με το Γενικό Διευθυντή του ΕΟΠΥΥ Ιωάννη Βαφειάδη και το Διοικητικό στέλεχος του Οργανισμού κ. Ν. Λεοντόπουλο . Κεντρικό θέμα συζήτησης η επιτάχυνση των διαδικασιών υπογραφής συμβάσεων του ΕΟΠΥΥ με μονάδες αιμοκάθαρσης ιδιωτικών κλινικών και το αίτημα του φορέα για την οικονομική κάλυψη. Ο …
ΠερισσότεραΕπίσκεψη του νέου υπουργού Υγείας στον ΕΟΠΥΥ
Συνάντηση με τον πρόεδρο του Ε.Ο.Π.Υ.Υ, Δημήτρη Κοντό πραγματοποίησε σήμερα ο Υπουργός Υγείας, Θάνος Δημόπουλος, προκειμένου να ενημερωθεί για τα τρέχοντα ζητήματα Οργανισμού. Ο κ. Κοντός ενημέρωσε τον Υπουργό που από την Παρασκευή ανέλαβε καθήκοντα υπηρεσιακού υπουργού Υγεία, για τα οικονομικά προβλήματα που αντιμετωπίζει ο Ε.Ο.Π.Υ.Υ, ενώ ιδιαίτερη αναφορά έγινε …
Περισσότερα Ιατρικά Νέα Θέματα για την υγεία | Το εγκυρότερο ελληνικό portal με θέματα υγείας, διατροφής, ομορφιάς, φυσικής κατάστασης, ιατρικών θεμάτων
Ιατρικά Νέα Θέματα για την υγεία | Το εγκυρότερο ελληνικό portal με θέματα υγείας, διατροφής, ομορφιάς, φυσικής κατάστασης, ιατρικών θεμάτων